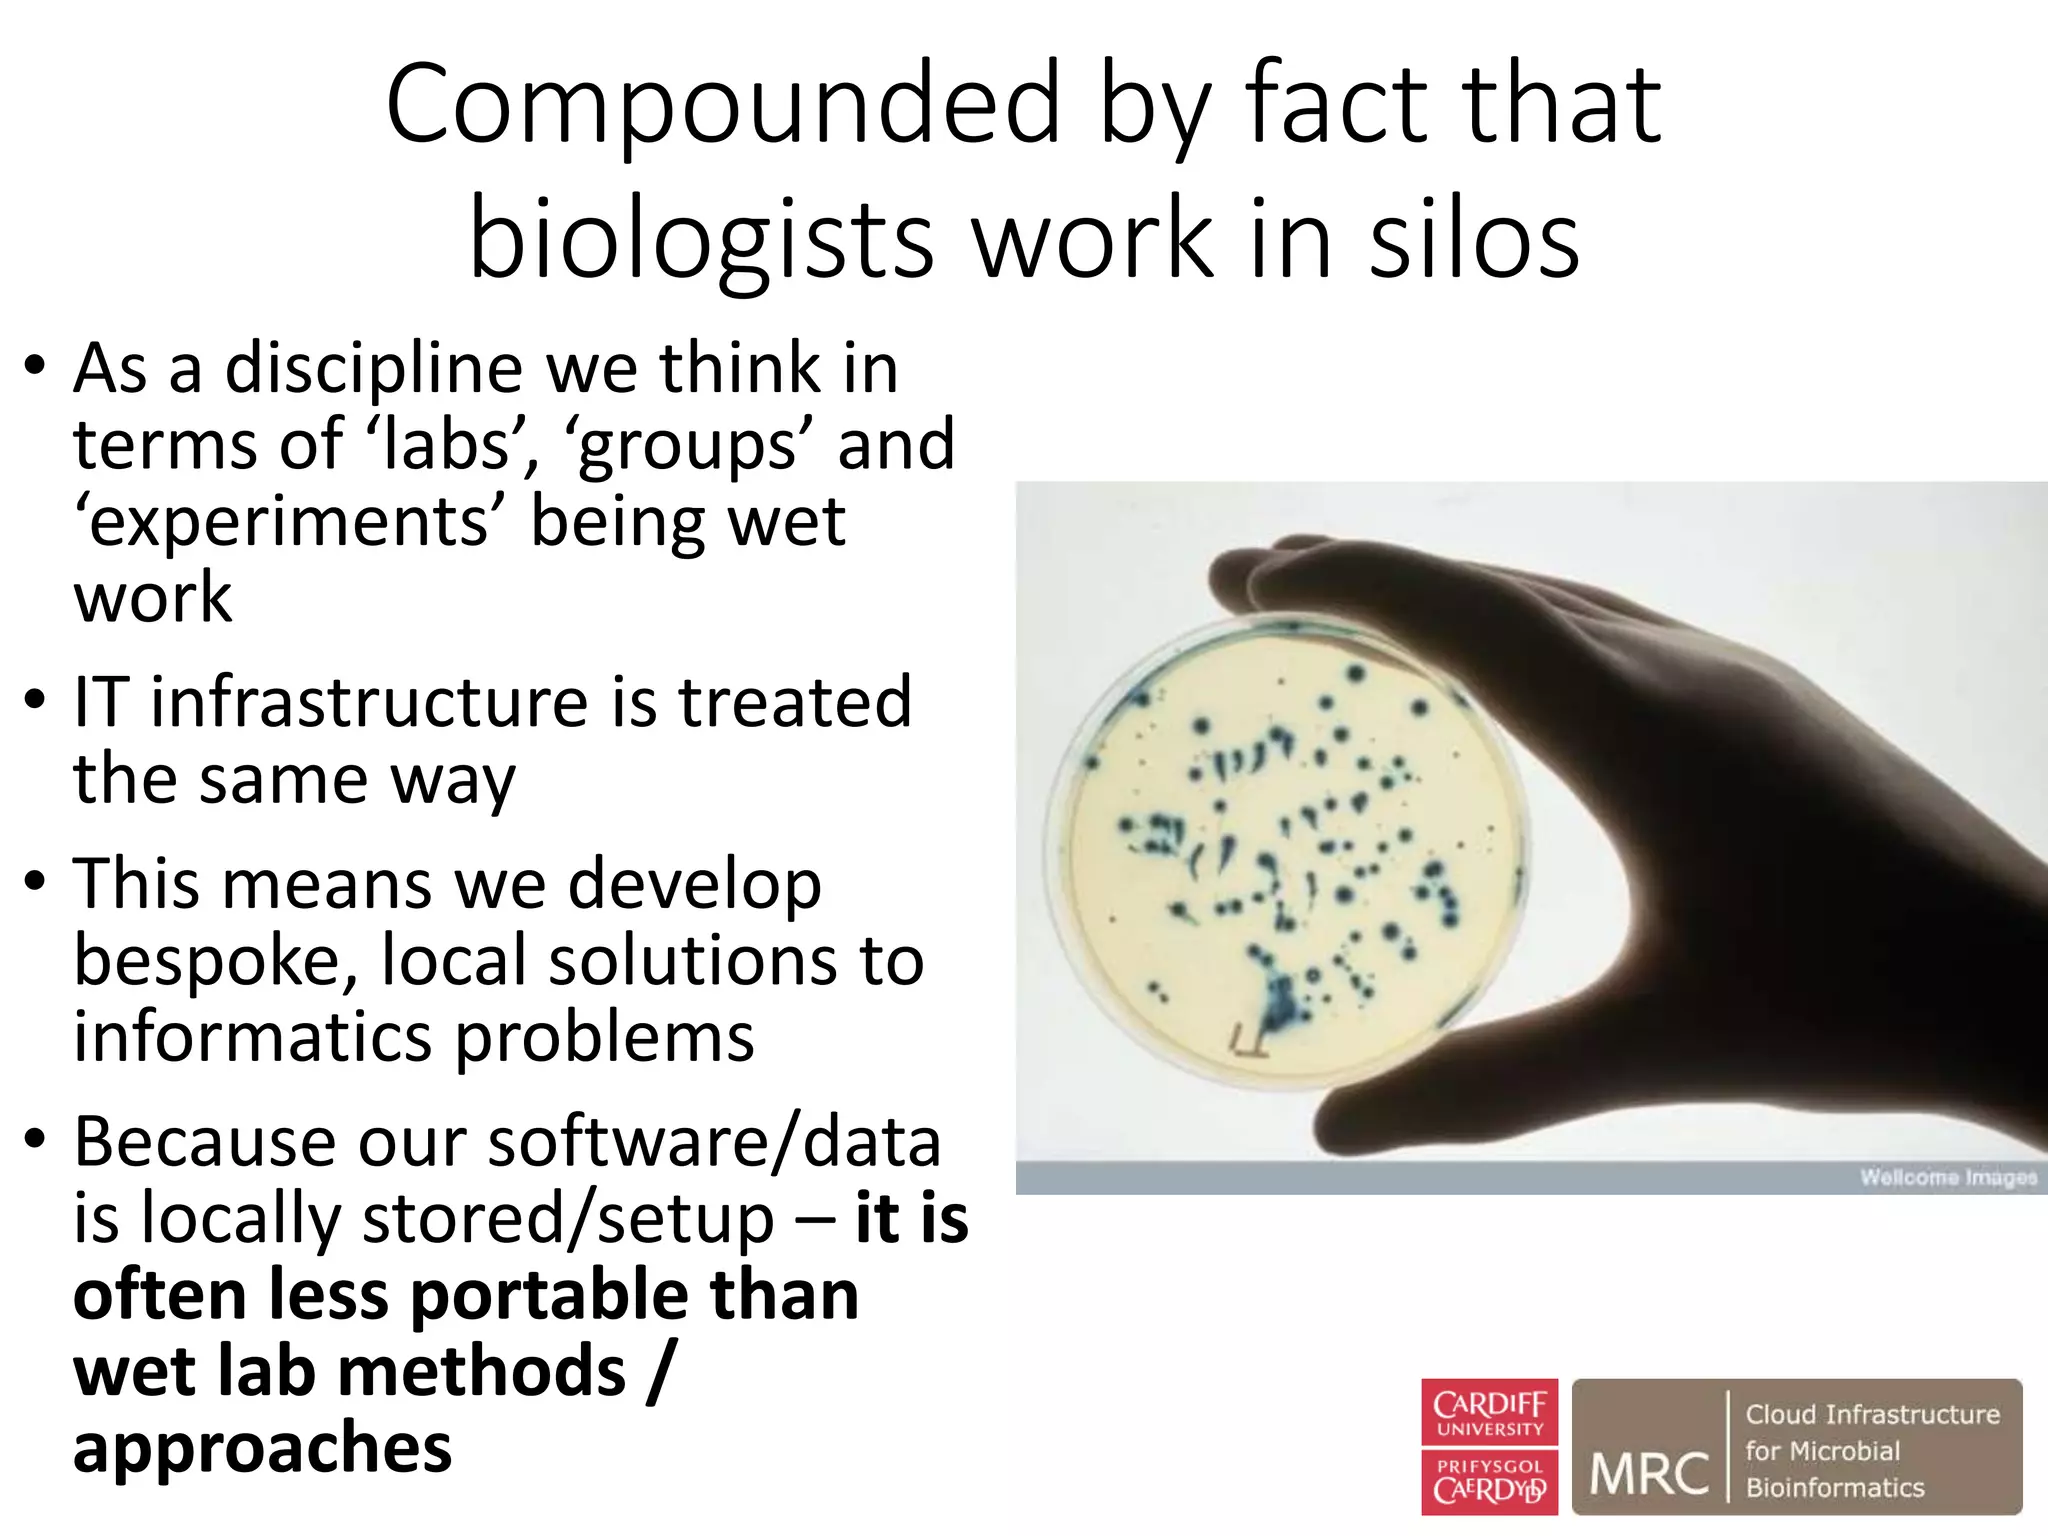
Compounded by fact that
biologists work in silos
• As a discipline we think in
terms of ‘labs’, ‘groups’ and
‘experiments’ being wet
work
• IT infrastructure is treated
the same way
• This means we develop
bespoke, local solutions to
informatics problems
• Because our software/data
is locally stored/setup – it is
often less portable than
wet lab methods /
approaches

The document outlines the development of a cloud infrastructure for microbial bioinformatics, aimed at improving data sharing and software use across the biology field. It highlights the challenges faced in handling biological big data, such as storage and computational capacity, while emphasizing the importance of cloud-based solutions for facilitating collaboration and resource sharing. The CLIMB project, funded by the MRC, proposes a national cyberinfrastructure capable of supporting over 1,000 virtual servers to enhance microbial research.